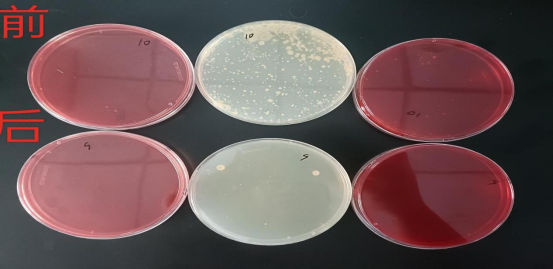

Center
新聞中心
最新新聞
聯(lián)系我們
濟(jì)南思達(dá)科環(huán)保設(shè)備有限公司
電話:0531-88805168
傳真:0531-88805168
手機(jī):18560229131
郵箱:sidake@126.com
地址:濟(jì)南市高新開發(fā)區(qū)機(jī)場(chǎng)路2399號(hào)方鼎工業(yè)園B棟
公司新聞
臭氧發(fā)生器在禽類養(yǎng)殖棚的可行性應(yīng)用報(bào)告
發(fā)布時(shí)間:2023-09-06 08:34:20 瀏覽次數(shù): 文章來源:濟(jì)南思達(dá)科環(huán)保設(shè)備有限公司
實(shí)驗(yàn)地點(diǎn):**鴨舍
實(shí)驗(yàn)器材:臭氧發(fā)生器一套,穿線管400米, 16平電纜 20米
實(shí)驗(yàn)現(xiàn)場(chǎng):

實(shí)驗(yàn)過程:
1.穿線管沿四層籠頂端鋪設(shè)2列,接至門口與設(shè)備出氣管相連。
2.設(shè)備與水管相連,冷卻水4m3/h.
3.消毒時(shí)間為1小時(shí)。
實(shí)驗(yàn)結(jié)果:
空氣消毒前后效果明顯,氨味明顯減輕
設(shè)備為一次性投資,可用于環(huán)境、帶鴨除臭效果良好,可用于鴨糞除臭。
考慮設(shè)備投資、消毒效果、人員的安全,效率的提高,附加值大等因素,臭氧發(fā)生器可行。
相關(guān)文章


